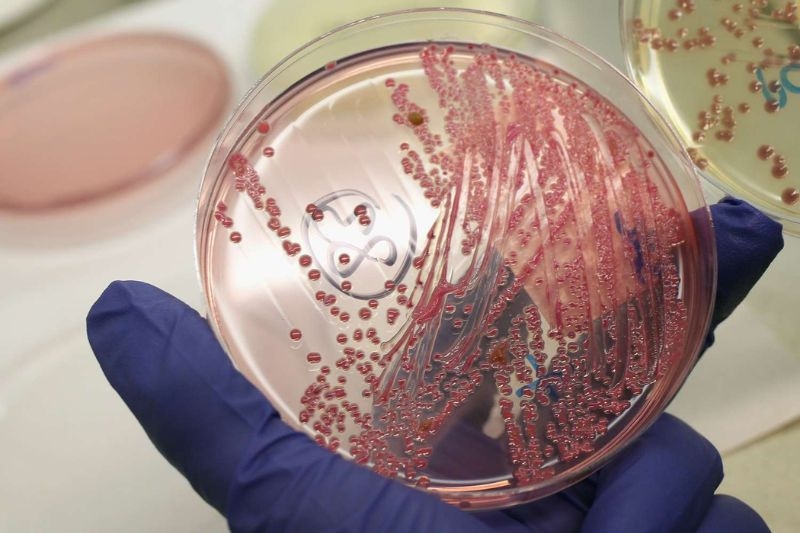
nuôi cấy vi khuẩn

Bệnh áp xe phổi và các phương pháp chẩn đoán bảo vệ sức khỏe
Áp xe phổi là một tình trạng nhiễm trùng phổi nghiêm trọng, hình thành ổ mủ trong nhu mô phổi. Nếu không phát hiện và điều trị kịp thời có thể dẫn đến biến chứng nặng nề, ảnh hưởng trực tiếp đến tính mạng người bệnh. Việc hiểu rõ nguyên nhân, các phương pháp chẩn đoán và điều trị bệnh áp xe phổi sẽ giúp bạn chủ động bảo vệ sức khỏe cho bản thân và gia đình.
1. Nguyên nhân mắc bệnh áp xe phổi
Áp xe phổi là một dạng nhiễm trùng phổi gây hoại tử mô phổi và hình thành một khoang chứa mủ. Các nguyên nhân dẫn đến bệnh áp xe phổi có thể được chia thành hai loại chính: áp xe phổi nguyên phát (do các vấn đề trực tiếp tại phổi) và áp xe phổi thứ phát (do nhiễm trùng từ các bộ phận khác lan truyền đến phổi).
1.1. Áp xe phổi nguyên phát
Áp xe phổi nguyên phát thường xuất hiện khi có những bệnh lý trực tiếp ảnh hưởng đến phổi, làm tăng nguy cơ hình thành ổ mủ.
– Viêm phổi: Các loại viêm phổi, đặc biệt là viêm phổi do hít phải dịch dạ dày, nếu không được điều trị kịp thời dễ tiến triển thành áp xe phổi.
– Khối u phổi: Khoảng 10-15% ca bệnh áp xe phổi có liên quan đến ung thư phổi, trong đó, ung thư biểu mô tế bào vảy là loại thường gặp nhất, do khối u cản trở đường thở, gây viêm phổi sau tắc nghẽn.
– Bệnh lý nền ở phổi: Các bệnh lý như giãn phế quản, xơ nang, bầm phổi hoặc nhồi máu phổi bị nhiễm trùng cũng có thể dẫn đến hình thành ổ áp xe.
– Suy giảm miễn dịch: Các hội chứng suy giảm miễn dịch bẩm sinh hoặc mắc phải như HIV/AIDS, hóa trị liệu đều có thể khiến cơ thể dễ mắc áp xe phổi hơn.
– Rối loạn sử dụng rượu: Những người nghiện rượu thường gặp phải các đợt nôn mửa và rối loạn ý thức, làm tăng nguy cơ hít phải dịch dạ dày và vi khuẩn vào phổi, gây nhiễm trùng. Hệ miễn dịch suy yếu do sức khỏe tổng thể kém và suy dinh dưỡng ở những người này cũng góp phần làm tăng khả năng mắc bệnh.
1.2. Áp xe phổi thứ phát
Bệnh áp xe phổi thứ phát xảy ra khi nhiễm trùng từ một vùng khác của cơ thể lan đến phổi. Quá trình lan rộng này có thể xảy ra theo nhiều cách khác nhau:
– Hít phải dịch nhiễm khuẩn từ miệng hoặc đường hô hấp trên: Điều này thường xảy ra ở những người có vấn đề về nuốt, người hôn mê, hoặc người bị rối loạn ý thức.
– Nhiễm khuẩn máu (nhiễm trùng huyết): Vi khuẩn có thể di chuyển qua máu đến phổi từ các vị trí nhiễm trùng khác như viêm tĩnh mạch huyết khối, viêm nội tâm mạc nhiễm khuẩn hoặc do tiêm chích ma túy.
– Xâm nhập trực tiếp: Vi khuẩn từ các vùng lân cận như thực quản, trung thất hoặc ổ áp xe dưới cơ hoành có thể lan sang phổi.

2. Chẩn đoán áp xe phổi bằng phương pháp nào?
2.1. Chẩn đoán hình ảnh bệnh áp xe phổi
Chẩn đoán hình ảnh đóng vai trò then chốt trong việc xác định sự hiện diện, vị trí và kích thước của ổ áp xe.
– X-quang phổi có thể phát hiện các tổn thương phổi, nhưng giai đoạn sớm áp xe chưa thấy rõ ổ mủ. Khi ổ áp xe phát triển, hình ảnh X-quang cho thấy khoang dày thành chứa mức khí-dịch, kèm dấu hiệu viêm phổi xung quanh.
– CT ngực là phương pháp chẩn đoán chính xác nhất, giúp phân biệt áp xe phổi với các bệnh lý khác như tràn mủ màng phổi, bóng khí phổi. CT còn hữu ích trong đánh giá áp xe phổi ở trẻ em và phát hiện khối u tiềm ẩn gây tắc nghẽn phế quản. Vị trí áp xe do hít phải thường xuất hiện ở thùy giữa phổi phải hoặc phần trên của thùy dưới hai bên phổi.
– Siêu âm ngực có thể hỗ trợ trong việc đánh giá áp xe, đặc biệt ở trẻ em hoặc trường hợp cần hướng dẫn dẫn lưu.
2.2. Nuôi cấy vi khuẩn
Việc xác định loại vi khuẩn gây bệnh là rất quan trọng để lựa chọn kháng sinh phù hợp:
– Mẫu đờm: Đôi khi, mẫu đờm (dịch khạc ra từ đường hô hấp) được lấy để xét nghiệm, tuy nhiên, kết quả thường không hoàn toàn chính xác do dễ bị nhiễm vi khuẩn từ đường miệng. Mặc dù vậy, nhuộm Gram và nuôi cấy đờm vẫn được thực hiện để tìm vi khuẩn hiếu khí. Nếu đờm có mùi hôi, vi khuẩn kỵ khí có thể là nguyên nhân.
– Cấy máu: Cấy máu thường được thực hiện để tìm vi khuẩn hiếu khí và kỵ khí. Tuy nhiên, kết quả cấy máu có thể âm tính khi vi khuẩn kỵ khí là loại chiếm ưu thế, vì chúng có thể mất nhiều thời gian hơn để phát triển trong môi trường máu.
– Nuôi cấy đặc biệt: Nếu có chỉ định lâm sàng, các mẫu đờm hoặc dịch cơ thể khác cũng có thể được nuôi cấy để tìm nấm và vi khuẩn lao. Nhuộm Gram và nuôi cấy bất kỳ dịch màng phổi nào (nếu có tràn mủ màng phổi) cũng cung cấp nguồn mẫu nuôi cấy kỵ khí tốt.
2.3. Nội soi phế quản
Nội soi phế quản được thực hiện khi cần loại trừ ung thư phổi hoặc tìm các tác nhân gây bệnh không điển hình như nấm, lao phổi. Phương pháp này đặc biệt hữu ích trong các trường hợp nuôi cấy âm tính, bệnh nhân có biểu hiện không điển hình hoặc bị suy giảm miễn dịch. Các mẫu lấy qua nội soi thường ít bị nhiễm khuẩn đường miệng, cho kết quả nuôi cấy vi khuẩn kỵ khí chính xác hơn so với mẫu đờm thông thường.
3. Điều trị áp xe phổi bảo vệ sức khỏe
3.1. Điều trị bằng kháng sinh và vật lý trị liệu hô hấp
Điều trị chính của áp xe phổi là sử dụng kháng sinh phổ rộng để tiêu diệt vi khuẩn gây bệnh, thường kéo dài từ 4 đến 6 tuần hoặc cho đến khi ổ áp xe biến mất trên hình ảnh.Trong các trường hợp áp xe do nấm, ký sinh trùng hoặc vi khuẩn đặc biệt, thời gian điều trị có thể kéo dài đến 6 tháng.
Song song với dùng kháng sinh, bệnh nhân sẽ được thực hiện các bài tập vật lý trị liệu hô hấp và dẫn lưu tư thế để hỗ trợ quá trình loại bỏ mủ, tăng hiệu quả điều trị.
3.2. Dẫn lưu qua da hoặc nội soi
Trong trường hợp áp xe phổi không đáp ứng với liệu pháp kháng sinh (chiếm dưới 10% các trường hợp), việc dẫn lưu có thể cần thiết. Điều này thường được xem xét nếu không có cải thiện nào được ghi nhận sau 10 đến 14 ngày dùng kháng sinh.
– Dẫn lưu qua da: Đây là thủ thuật đưa một kim nhỏ xuyên qua thành ngực vào ổ áp xe dưới hướng dẫn của hình ảnh (ví dụ: siêu âm hoặc CT) để dẫn lưu mủ ra ngoài. Phương pháp này thường được thực hiện phổ biến hơn.
– Dẫn lưu nội soi phế quản: Dẫn lưu có thể được thực hiện thông qua nội soi phế quản và siêu âm nội phế quản. Phương pháp này có thể được xem xét là lựa chọn tốt hơn cho các áp xe nằm ở vị trí trung tâm, xa màng phổi, khi có nguy cơ chọc thủng mô phổi.
3.3. Phẫu thuật dành cho bệnh áp xe phổi
Trong những trường hợp rất hiếm (khoảng 5-10% tổng số ca), phẫu thuật có thể được yêu cầu. Các thủ thuật phổ biến nhất là cắt bỏ một phần hoặc toàn bộ thùy phổi bị ảnh hưởng (cắt thùy hoặc cắt phân thùy), trong đó ổ áp xe và một số mô xung quanh được loại bỏ. Các trường hợp này thường có thể được thực hiện bằng phẫu thuật ít xâm lấn

Bệnh áp xe phổi có thể gây ra nhiều biến chứng nghiêm trọng nếu không được chẩn đoán và điều trị kịp thời. Việc nhận biết các nguyên nhân, dấu hiệu cảnh báo sớm và thực hiện các phương pháp chẩn đoán giúp phát hiện bệnh sớm, điều trị hiệu quả, bảo vệ sức khỏe hô hấp của bạn.